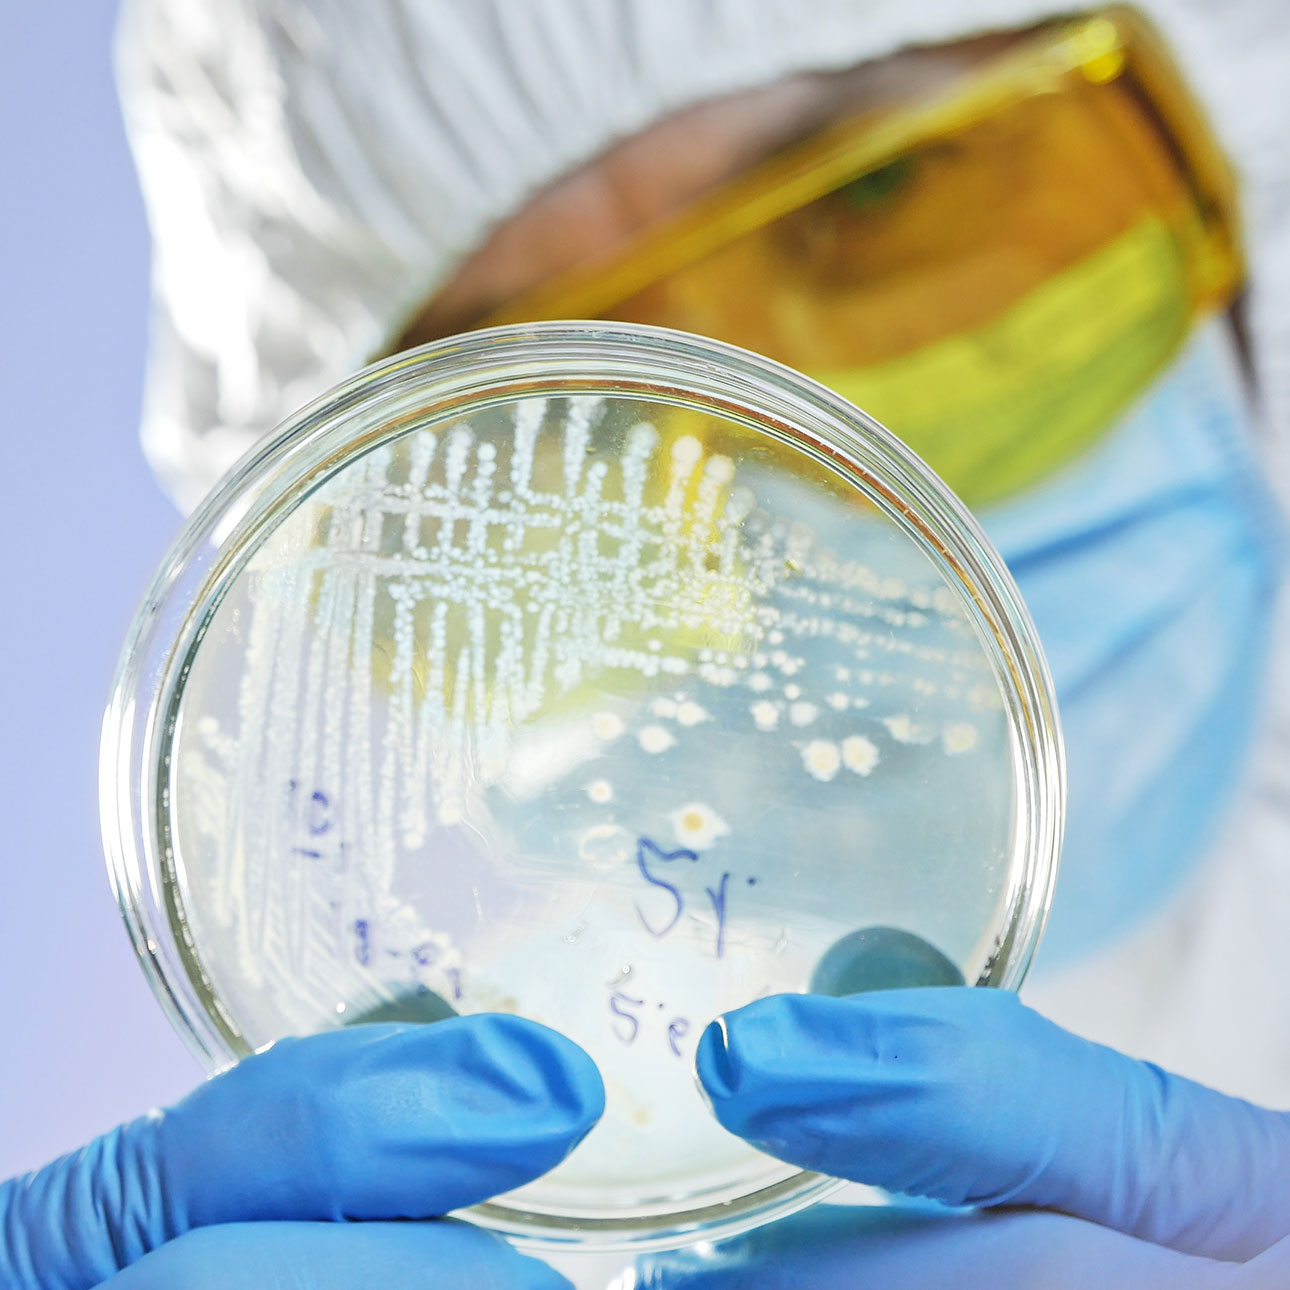

Seguridad sanitaria y cumplimiento normativo
La legionelosis es una enfermedad grave causada por la bacteria Legionella pneumophila, cuyas manifestaciones clínicas pueden derivar en cuadros de neumonía atípica e incluso la muerte. La infección se produce principalmente por vía respiratoria mediante la inhalación de aerosoles generados en instalaciones que utilizan agua para su funcionamiento.
Según el Real Decreto 487/2022, infraestructuras como torres de refrigeración, condensadores evaporativos, sistemas de distribución de agua fría de consumo humano o agua caliente sanitaria, nebulizadores, spas, jacuzzis y bañeras de hidromasaje, entre otros, son consideradas de alta probabilidad para la proliferación y dispersión de esta bacteria. Por ello, es vital contar con un control riguroso que garantice la salud en ámbitos comunitarios e institucionales.
Cumple con la normativa sanitaria y protege la salud de la población. Solicita presupuesto para implantar un Plan de Prevención y Control de Legionella en tus instalaciones.

Mantenimiento de instalaciones de riesgo
BIODAL ofrece un servicio integral de mantenimiento, diseñado para minimizar cualquier riesgo en las instalaciones. El protocolo de actuación incluye diferentes medidas preventivas, la elaboración de planos señalizados y actualizados, la revisión y examen de todas las partes de la instalación, la identificación de puntos críticos y el establecimiento de los parámetros a medir. Se incluyen programas específicos de tratamiento de agua, limpieza y desinfección con la periodicidad exigida por el RD 487/2022, realizando tratamientos de choque inmediatos en caso de detección de la bacteria.
Los trabajos son desarrollados por técnicos cualificados, los cuales cuentan con la formación oficial obligatoria, asegurando un servicio de máxima calidad y seguridad.